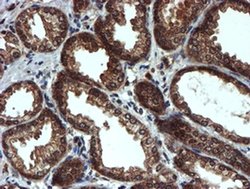
Invitrogen PSMA6 Monoclonal Antibody (OTI4C9) 100 &mu;L; Unconjugated:Antibodies,

missing translation for 'onlineSavingsMsg'
Learn More
Learn More
Invitrogen™ PSMA6 Monoclonal Antibody (OTI4C9)


Mouse Monoclonal Antibody
Brand: Invitrogen™ MA526371
This item is not returnable.
View return policy
Description
PSMA6 Monoclonal Antibody for Western Blot, IHC (P), Flow
The proteasome is a multicatalytic proteinase complex with a highly ordered ring-shaped 20S core structure. The core structure is composed of 4 rings of 28 non-identical subunits; 2 rings are composed of 7 alpha subunits and 2 rings are composed of 7 beta subunits. Proteasomes are distributed throughout eukaryotic cells at a high concentration and cleave peptides in an ATP/ubiquitin-dependent process in a non-lysosomal pathway. An essential function of a modified proteasome, the immunoproteasome, is the processing of class I MHC peptides. This gene encodes a member of the peptidase T1A family, that is a 20S core alpha subunit. A pseudogene has been identified on the Y chromosome.
Specifications
| PSMA6 | |
| Monoclonal | |
| 1 mg/mL | |
| PBS with 1% BSA, 50% glycerol and 0.02% sodium azide; pH 7.3 | |
| P60900, P60901, Q9QUM9 | |
| PSMA6 | |
| Full length human recombinant protein of PSMA6 produced in E.coli. | |
| 100 μL | |
| Primary | |
| Human, Mouse, Rat, Canine, Monkey | |
| Antibody | |
| IgG2b |
| Flow Cytometry, Immunohistochemistry (Paraffin), Western Blot | |
| OTI4C9 | |
| Unconjugated | |
| PSMA6 | |
| 27 kDa prosomal protein; EGK_18113; IOTA; Macropain iota chain; macropain subunit iota; MGC22756; MGC2333; MGC23846; multicatalytic endopeptidase complex iota chain; p27K; PROS 27; PROS27; PROS-27; prosomal P27K protein; proteasome (prosome, macropain) subunit, alpha type 6; proteasome (prosome, macropain) subunit, alpha type, 6; proteasome 20S subunit alpha 6; proteasome alpha 6 subunit; proteasome iota chain; proteasome subunit alpha 6; proteasome subunit alpha type-6; proteasome subunit iota; PSA6; PSMA 6; PSMA6; testicular secretory protein Li 44 | |
| Mouse | |
| Affinity Chromatography | |
| RUO | |
| 26443, 29673, 480290, 5687 | |
| -20°C, Avoid Freeze/Thaw Cycles | |
| Liquid |
Product Content Correction
Your input is important to us. Please complete this form to provide feedback related to the content on this product.
Product Title
Spot an opportunity for improvement?Share a Content Correction